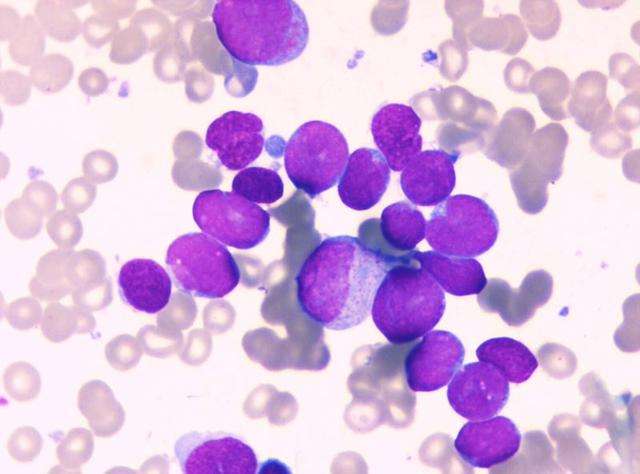
急性淋巴細(xì)胞白血病

急性淋巴細(xì)胞白血病簡(jiǎn)介:
急性淋巴細(xì)胞白血?。ˋLL)是一種起源于淋巴細(xì)胞的B系或T系細(xì)胞在骨髓內(nèi)異常增生的惡性腫瘤性疾病�����。異常增生的原始細(xì)胞可在骨髓聚集并抑制正常造血功能,同時(shí)也可侵及骨髓外的組織�����,如腦膜���、淋巴結(jié)�����、性腺��、肝等��。我國(guó)曾進(jìn)行過(guò)白血病發(fā)病情況調(diào)查,ALL發(fā)病率約為0.67/10萬(wàn)����。在油田�����、污染區(qū)發(fā)病率明顯高于全國(guó)發(fā)病率����。ALL兒童期(0~9歲)為發(fā)病高峰����,可占兒童白血病的70%以上。ALL在成人中占成人白血病的20%左右��。目前依據(jù)ALL不同的生物學(xué)特性制定相應(yīng)的治療方案已取得較好療效��,大約80%的兒童和30%的成人能夠獲得長(zhǎng)期無(wú)病生存�����,并且有治愈的可能�。